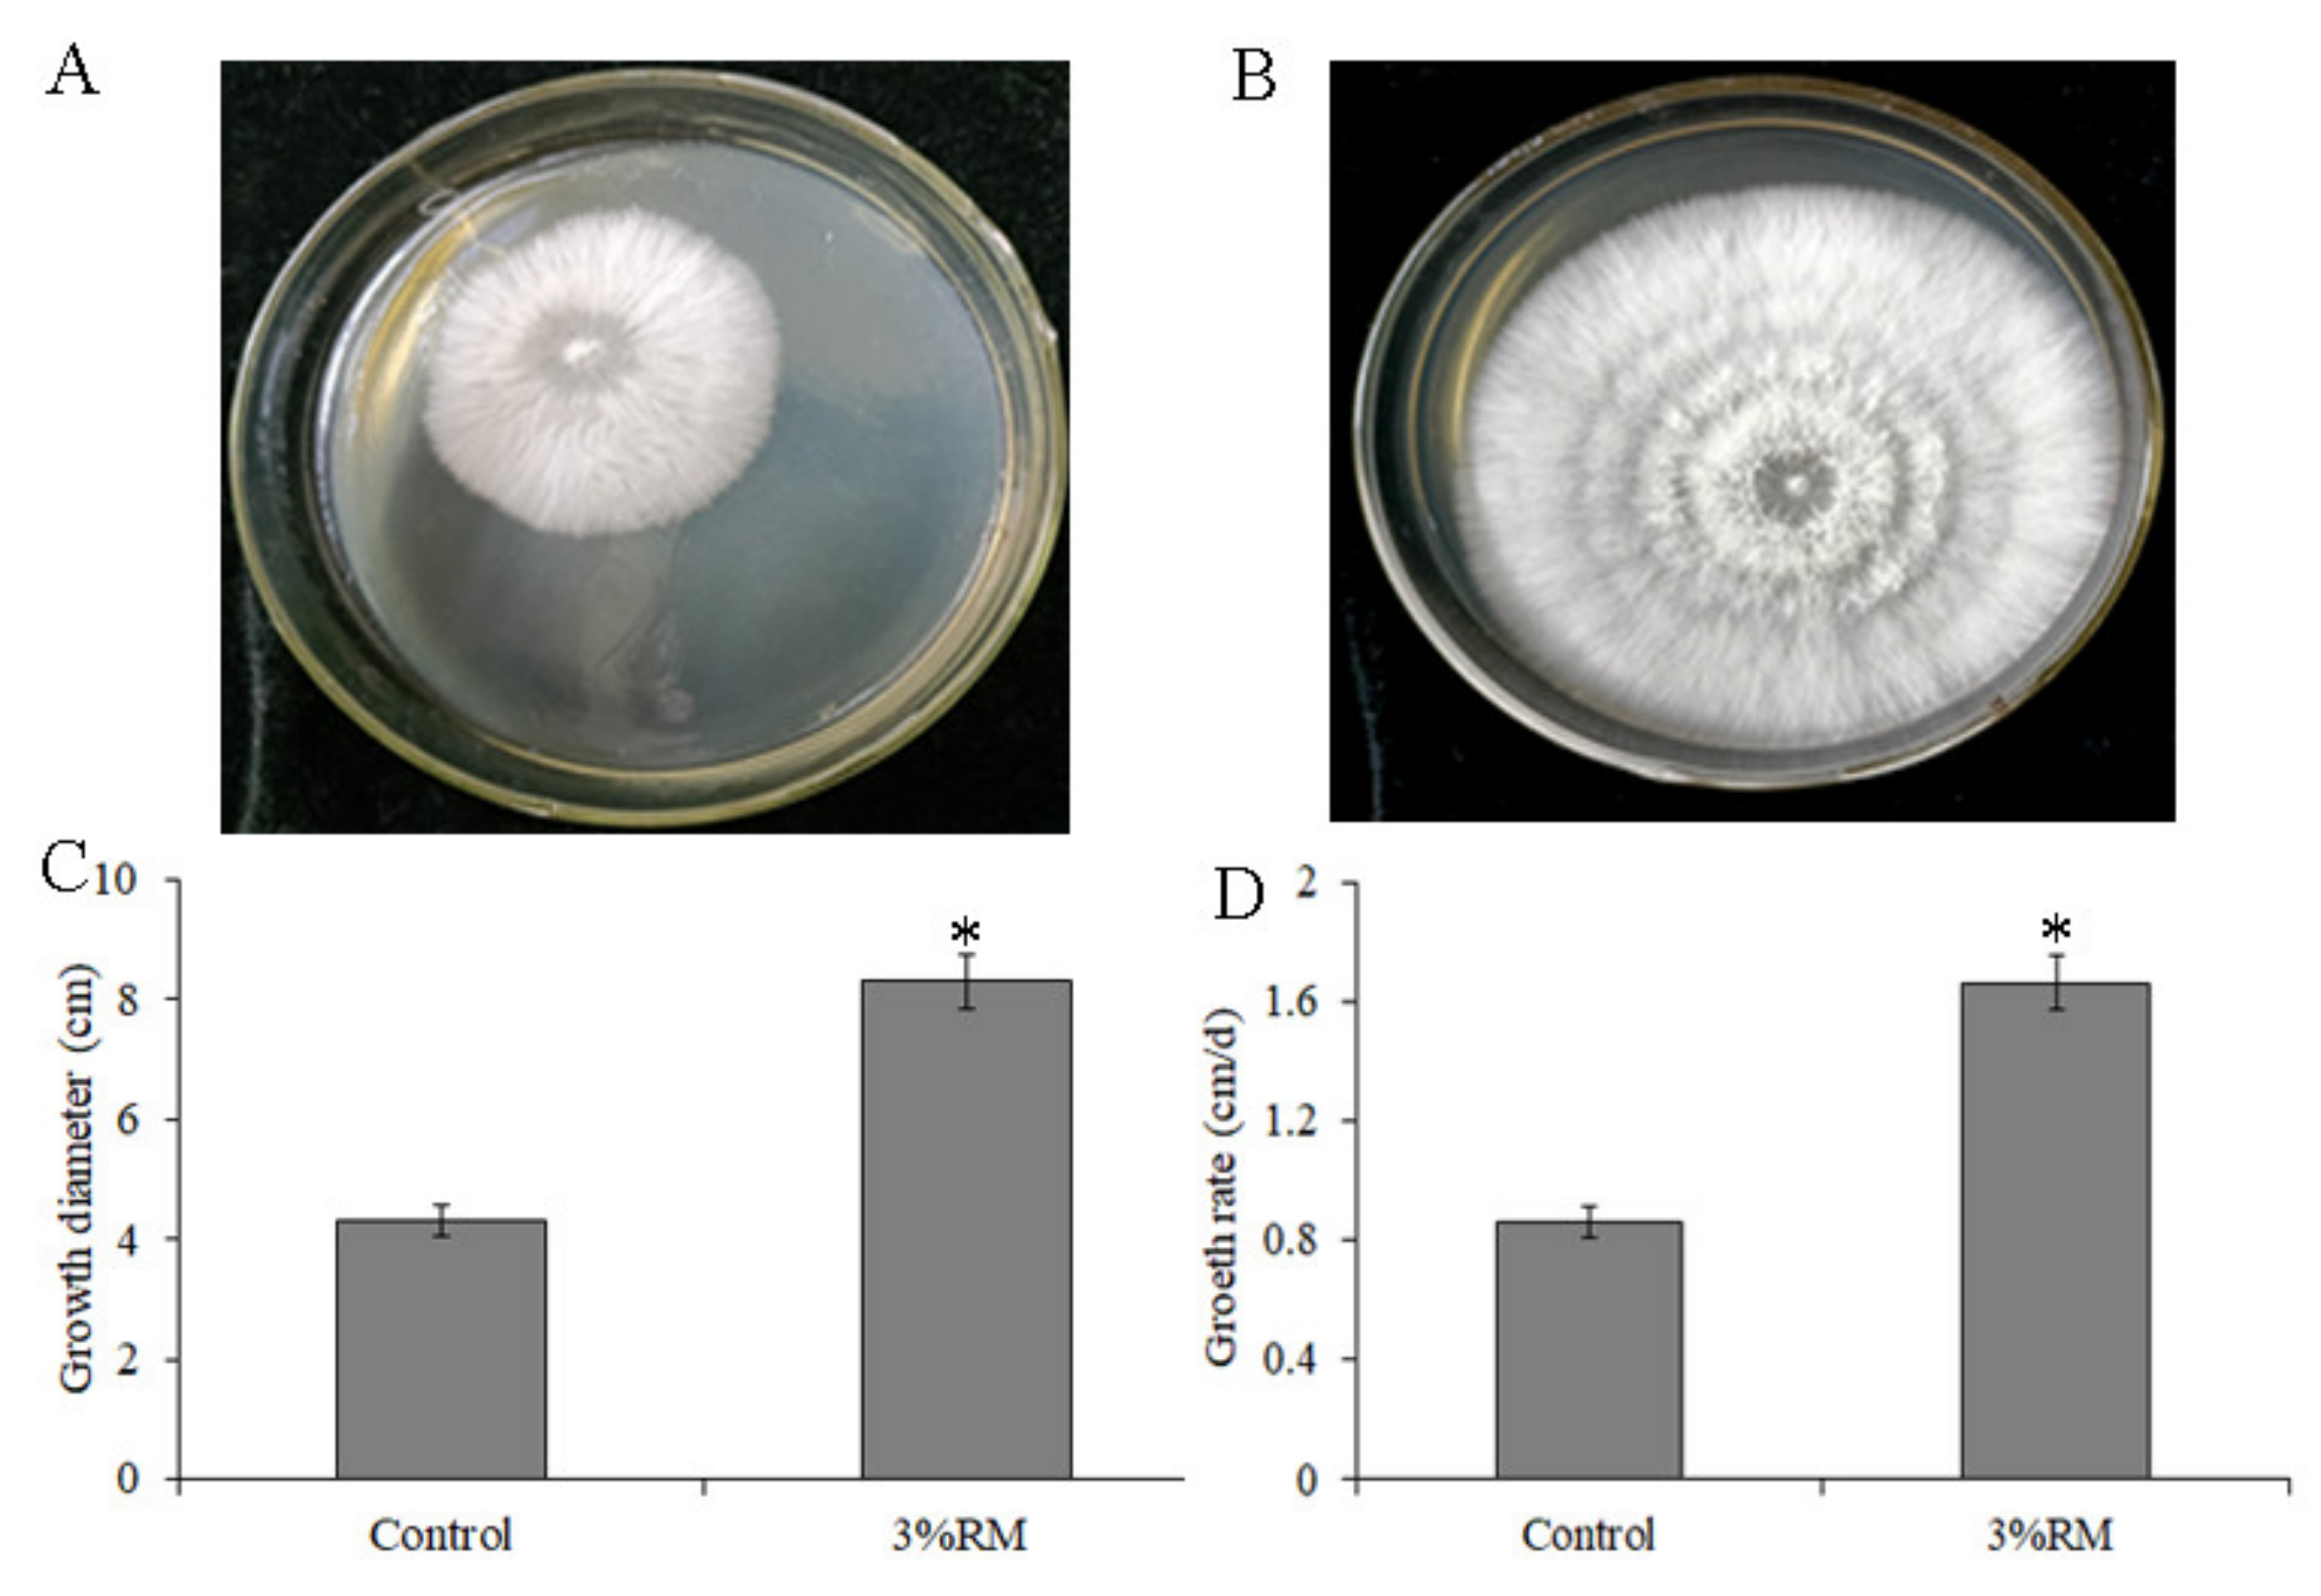

Effects of Rosa roxburghii Tratt Must on the Growth, Nutrient Composition, and Antioxidant Activity of Pleurotus ostreatus Mycelia
Abstract
:1. Introduction
2. Materials and Methods
2.1. Sources of Materials
2.2. Effect of R. roxburghii Must on the Growth of P. ostreatus Mycelia
2.3. Effects of R. roxburghii Must on the Nutrient Composition of P. ostreatus Mycelia
2.4. Effects of R. roxburghii Must on the Crude Polysaccharide Content and Antioxidant Activity of P. ostreatus Mycelia
2.5. Statistical Analysis
3. Results and Analysis
3.1. Physicochemical Parameters of R. roxburghii Must
3.2. Effects of R. roxburghii Must on the Growth of P. ostreatus Mycelia
3.3. Effects of R. roxburghii Must on the Nutrient Composition of P. ostreatus Mycelia
3.4. Effects of R. roxburghii Must on the Polysaccharide Content and Antioxidant Activity of P. ostreatus Mycelia
4. Discussion
5. Conclusions
Author Contributions
Funding
Institutional Review Board Statement
Informed Consent Statement
Data Availability Statement
Conflicts of Interest
Sample Availability
References
- Josiane, M.; Estelle, M.; Francis, N. Effect of substrates on nutritional composition and functional properties of Pleurotus ostreatus. Curr. Res. Agric. Sci. 2018, 5, 15–22. [Google Scholar]
- Sánchez, C. Cultivation of Pleurotus ostreatus and other edible mushrooms. Appl. Microbiol. Biotechnol. 2010, 85, 1321–1337. [Google Scholar] [CrossRef] [PubMed]
- Das, N.; Mukherjee, M. Cultivation of Pleurotus ostreatus on weed plants. Bioresour. Technol. 2007, 98, 2723–2726. [Google Scholar] [CrossRef] [PubMed]
- Wang, L.; Zhang, B.; Xiao, J.; Huang, Q.; Li, C.; Fu, X. Physicochemical, functional, and biological properties of water-soluble polysaccharides from Rosa roxburghii Tratt fruit. Food Chem. 2018, 249, 127–135. [Google Scholar] [CrossRef] [PubMed]
- Wang, L.T.; Lv, M.J.; An, J.Y.; Fan, X.H.; Dong, M.Z.; Zhang, S.D.; Wang, J.D.; Wang, Y.Q.; Cai, Z.H.; Fu, Y.J. Botanical characteristics, phytochemistry and related biological activities of Rosa roxburghii Tratt fruit, and its potential use in functional foods: A review. Food Funct. 2021, 12, 1432–1451. [Google Scholar] [CrossRef] [PubMed]
- Liu, X.Z.; Li, Y.F.; Zhao, H.B.; Yu, Z.H.; Huang, M.Z. Oenological property analysis of selected Hanseniaspora uvarum isolated from Rosa roxburghii Tratt. Int. J. Food Eng. 2020, 17, 445–454. [Google Scholar] [CrossRef]
- Huang, D.S.; Li, C.; Chen, Q.; Xie, X.; Fu, X.; Chen, C.; Huang, Q.; Huang, Z.B.; Dong, H. Identification of polyphenols from Rosa roxburghii Tratt pomace and evaluation of in vitro and in vivo antioxidant activity. Food Chem. 2022, 377, 131922. [Google Scholar] [CrossRef]
- Yang, Y.; Yang, L.S.; Luo, S.Z. Study on the changes of protein content in the cultivation of Pleurotus ostreatus with Roxburgh rose fruit residue. J. Anhui Agric. Sci. 2019, 47, 51–52. [Google Scholar]
- Zhang, W.; Tian, W.Q. Study on cultivation of Pleurotus ostreatus by pomace of Rosae roxburghii Tratt. Edible Fungi 1996, 20. [Google Scholar]
- Yang, J.; Yang, Y.; Luo, S.Z.; Li, L.L.; Pan, X.; Peng, M.; Zhang, Y.; Yang, X.S. Study on the cultivation of Pleurotus ostreatus by pomace of Rosae roxburghii Tratt and its enzymatic extraction process of amino acids. Edible Fungi. China 2019, 38, 50–57. [Google Scholar]
- Nguyen, T.M.; Ranamukhaarachchi, S.L. Effect of different culture media, grain sources and alternate substrates on the mycelial growth of Pleurotus eryngii and Pleurotus ostreatus. Pak. J. Biol. Sci. 2020, 23, 223–230. [Google Scholar] [CrossRef] [PubMed] [Green Version]
- Mádlíková, M.; Krausová, I.; Mizera, J.; Faměra, O.; Chvátil, D. Nitrogen assay in winter wheat by short-time instrumental photon activation analysis and its comparison with the Kjeldahl method. J. Radioanal. Nucl. Chem. 2018, 317, 479–486. [Google Scholar] [CrossRef]
- Hirondart, M.; Rombaut, N.; Fabiano-Tixier, A.S.; Bily, A.; Chemat, F. Comparison between pressurized liquid extraction and conventional soxhlet extraction for rosemary antioxidants, yield, composition, and environmental footprint. Foods 2020, 9, 584. [Google Scholar] [CrossRef]
- Wang, D.; Sakoda, A.; Suzuki, M. Biological efficiency and nutritional value of Pleurotus ostreatus cultivated on spent beer grain. Bioresour. Technol. 2001, 78, 293–300. [Google Scholar] [CrossRef]
- Zhang, Y.; Dai, L.; Kong, X.; Chen, L.W. Characterization and in vitro antioxidant activities of polysaccharides from Pleurotus ostreatus. Int. J. Biol. Macromol. 2012, 51, 259–265. [Google Scholar] [CrossRef]
- Tesfay, T.; Godifey, T.; Mesfin, R.; Kalayu, G. Evaluation of waste paper for cultivation of oyster mushroom (Pleurotus ostreatus) with some added supplementary materials. AMB Express 2020, 10, 1–8. [Google Scholar] [CrossRef] [Green Version]
- Skinner, R.C.; Gigliotti, J.C.; Ku, K.M.; Tou, J.C. A comprehensive analysis of the composition, health benefits, and safety of apple pomace. Nutr. Rev. 2018, 76, 893–909. [Google Scholar] [CrossRef]
- Park, Y.J.; Park, H.R.; Kim, S.R.; Yoon, D.E.; Son, E.S.; Chul Kwon, O.; Han, W.; Lee, C.S. Apple pomace increases mycelial growth of Pleurotus ostreatus. Afr. J. Microbiol. Res. 2012, 6, 1075–1078. [Google Scholar]
- Doroški, A.; Klaus, A.; Kozarski, M.; Cvetković, S.; Nikolić, B.; Jakovljević, D.; Tomasevic, I.; Vunduk, J.; Lazić, V.; Djekic, I. The influence of grape pomace substrate on quality characterization of Pleurotus ostreatus-total quality index approach. J. Food Process. Preserv. 2021, 45, 15096. [Google Scholar] [CrossRef]
- Otieno, O.D.; Mulaa, F.J.; Obiero, G.; Midiwo, J. Utilization of fruit waste substrates in mushroom production and manipulation of chemical composition. Biocatal. Agric. Biotechnol. 2022, 39, 102250. [Google Scholar] [CrossRef]
- Xu, J.; Vidyarthi, S.K.; Bai, W.; Pan, Z.L. Nutritional constituents, health benefits and processing of Rosa Roxburghii: A review. J. Funct. Foods. 2019, 60, 103456. [Google Scholar] [CrossRef]
- Nashiruddin, N.I.; Chua, K.S.; Mansor, A.F.; Rahman, R.A.; Lai, J.C.; Azelee, N.I.W.; Enshasy, H.E. Effect of growth factors on the production of mycelium-based biofoam. Clean Technol. Environ. 2022, 24, 351–361. [Google Scholar] [CrossRef]
- Zhang, L.; Guo, P.Y.; Liu, D.; Xue, C.M. Effect of histidine content on mycelial growth of Pleurotus ostreatus. For. By-Prod. Spec. China 2020, 1, 17–18, 20. [Google Scholar]
- Tao, W.W.; Wang, T.T.; Wang, S.Q. Influence of the addition of trace element in medium on the Pleurotus ostreatus hphal growth and enzyme activity. J. Anhui Agric. Sci. 2011, 39, 18472–18474. [Google Scholar]
- Hoa, H.T.; Wang, C.L. The effects of temperature and nutritional conditions on mycelium growth of two oyster mushrooms (Pleurotus ostreatus and Pleurotus cystidiosus). Mycobiology 2015, 43, 14–23. [Google Scholar] [CrossRef] [Green Version]
- Liu, X.; Li, Y.; Yu, Z.; Hardie, W.J.; Huang, M. Screening and characterisation of β-glucosidase production strains from Rosa roxburghii Tratt. Int. J. Food Eng. 2021, 17, 1–9. [Google Scholar] [CrossRef]
- Silva, S.; Martins, S.; Karmali, A.; Rosa, E. Production, purification and characterisation of polysaccharides from Pleurotus ostreatus with antitumour activity. J. Sci. Food Agric. 2012, 92, 1826–1832. [Google Scholar] [CrossRef] [Green Version]
- Sharma, A.; Sharma, A.; Tripathi, A. Biological activities of Pleurotus spp. polysaccharides: A review. J. Food Biochem. 2021, 45, e13748. [Google Scholar] [CrossRef]

| Weight (g) | pH | Content (g/100 g FW) | |||
|---|---|---|---|---|---|
| Total Sugar | Total Acid | Soluble Protein | |||
| Fruit | 21.26 ± 1.58 | - | - | - | - |
| Must | - | 3.49 ± 0.13 | 5.22 ± 0.34 | 9.87 ± 0.73 | 0.34 ± 0.02 |
| Groups | Crude Protein | Soluble Substances | Fat | Ash | Crude Fiber |
|---|---|---|---|---|---|
| Control | 15.36 ± 0.43 | 13.25 ± 0.71 | 3.51 ± 0.14 | 5.68 ± 0.32 | 15.36 ± 0.73 |
| 4% RM | 18.97 ± 0.56 * | 14.13 ± 0.64 | 3.54 ± 0.26 | 6.03 ± 0.28 | 15.41 ± 0.66 |
| Amino Acids | Groups | |
|---|---|---|
| Control | 4% RM | |
| Aspartic acid | 1.35 ± 0.04 | 1.41 ± 0.05 |
| Threonine a | 0.51 ± 0.02 | 0.65 ± 0.02 * |
| Valine a | 0.82 ± 0.02 | 0.84 ± 0.04 |
| Glycine | 0.52 ± 0.01 | 0.51 ± 0.02 |
| Serine | 0.46 ± 0.02 | 0.43 ± 0.01 |
| Alanine | 0.66 ± 0.03 | 0.85 ± 0.03 * |
| Cysteine | 0.10 ± 0.00 | 0.08 ± 0.01 |
| Leucine a | 0.94 ± 0.03 | 0.92 ± 0.01 |
| Isoleucine a | 0.63 ± 0.04 | 0.75 ± 0.02 * |
| Methionine a | 0.53 ± 0.02 | 0.58 ± 0.02 |
| Tyrosine | 0.28 ± 0.01 | 0.33 ± 0.01 |
| Phenylalanine a | 0.82 ± 0.03 | 0.68 ± 0.02 * |
| Histidine | 0.18 ± 0.01 | 0.14 ± 0.01 |
| Lysine a | 0.42 ± 0.00 | 0.54 ± 0.02 * |
| Proline | 0.53 ± 0.02 | 0.62 ± 0.03 * |
| Tryptophan a | 0.35 ± 0.02 | 0.46 ± 0.02 * |
| Arginine | 0.61 ± 0.02 | 0.76 ± 0.03 * |
| Glutamic acid | 1.52 ± 0.03 | 1.74 ± 0.05 * |
| Total essential amino acids | 5.02 ± 0.18 | 5.42 ± 0.17 |
| Total amino acids | 11.23 ± 0.37 | 12.29 ± 0.41 * |
| Groups | Thiamine | Riboflavin | Niacin |
|---|---|---|---|
| Control | 1.96 ± 0.12 | 3.41 ± 0.18 | 94.56 ± 4.35 |
| 4% RM | 1.94 ± 0.15 | 3.54 ± 0.26 | 101.79 ± 6.48 |
Publisher’s Note: MDPI stays neutral with regard to jurisdictional claims in published maps and institutional affiliations. |
© 2022 by the authors. Licensee MDPI, Basel, Switzerland. This article is an open access article distributed under the terms and conditions of the Creative Commons Attribution (CC BY) license (https://creativecommons.org/licenses/by/4.0/).
Share and Cite
Li, Y.; Chen, F.; Liu, X. Effects of Rosa roxburghii Tratt Must on the Growth, Nutrient Composition, and Antioxidant Activity of Pleurotus ostreatus Mycelia. Molecules 2022, 27, 3585. https://doi.org/10.3390/molecules27113585
Li Y, Chen F, Liu X. Effects of Rosa roxburghii Tratt Must on the Growth, Nutrient Composition, and Antioxidant Activity of Pleurotus ostreatus Mycelia. Molecules. 2022; 27(11):3585. https://doi.org/10.3390/molecules27113585
Chicago/Turabian StyleLi, Yinfeng, Fei Chen, and Xiaozhu Liu. 2022. "Effects of Rosa roxburghii Tratt Must on the Growth, Nutrient Composition, and Antioxidant Activity of Pleurotus ostreatus Mycelia" Molecules 27, no. 11: 3585. https://doi.org/10.3390/molecules27113585
APA StyleLi, Y., Chen, F., & Liu, X. (2022). Effects of Rosa roxburghii Tratt Must on the Growth, Nutrient Composition, and Antioxidant Activity of Pleurotus ostreatus Mycelia. Molecules, 27(11), 3585. https://doi.org/10.3390/molecules27113585
